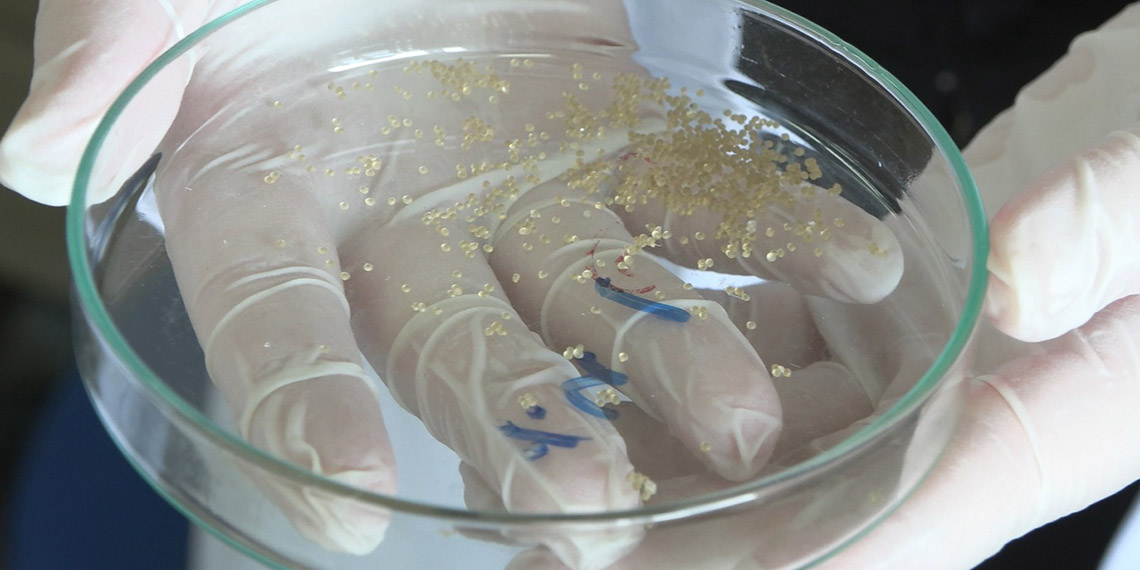

İstanbul’da 4 üniversite öğrencisi, birçok kronik hastalığın neden olabilecek vücut yaralarının bakımında kullanılabilecek anti bakteriyel yara bandı üretiyor. Aktif madde olarak tarçın yağı kullanılan ve TÜBİTAK tarafından desteklenen projeden şimdiye kadar yüzde 70 oranında verim alındı.
İstanbul Beykent Üniversitesi kimya mühendisliği bölümünden 4 öğrenci, 2021 yılının mart ayında doğal ve anti bakteriyel özelliğe sahip tarçın yağı kullanarak yaraların bakteriyel enfeksiyonunu önlemeye yardımcı olacak yara bandı oluşturmak amacıyla projelerine başladı. Aralıksız devam eden çalışmalar kapsamında tarçın yağının ortama salınması veriminde yüzde 70 oranına ulaşıldı. Bu verimi daha da artırmayı hedeflediklerini söyleyen öğrenciler, özellikle diyabet gibi Türkiye’de sıklıkla rastlanan kronik hastalıkların sebep olduğu yaraların günlük bakımında doğal kaynaklı bir alternatif sunmayı hedeflediklerini belirtti.
“İMKAN BULURSAK ÇALIŞMAMIZI İLERLETMEK İSTİYORUZ”
Projenin danışmanlığını yürüten Beykent Üniversitesi’nden Kimya Mühendisliği Bölümü Dr. Öğr. Üyesi Yasemin Kaptan, proje ile ilgili şu bilgileri verdi:
“Bu proje ile anti bakteriyel özellikte bir yara örtüsü geliştirmeyi hedefledik. Ülkemizde diyabet ve yatalak hastalarımızın uğraştığı önemli problemlerden biri iyileştirilemeyen ya da uzun süreli kronik yaralardır. Bu yaraların günlük bakım ve pansumanlarında kullanılabilecek bir ürün geliştirmeye çalışıyoruz. Aktif madde olarak anti bakteriyel özelliği sağlaması için tarçın yağı malzemesi kullandık.
Doğal kaynaklı bir ürün olduğu için çevreye zararının az olması ve kimyasal kaynaklı konvansiyonel ilaçların vücutta yan etkileri olmasından ötürü tarçın yağını aktif madde olarak seçtik. Bunu nasıl bir ürüne çevirebilir ve yara örtüsü formatına getirebilirizden yol çıkarak projemizi geliştirdik. Bu şekilde laboratuvarda küçük ölçekli olacak şekilde projemizi yapıyoruz. Buradan alacağımız sonuçlara göre projemizin geliştirilebilme potansiyeli yüksek. İmkan bulursak çalışmamızı ilerletmek istiyoruz.”
Projeden yüzde 70 oranında verim elde ettiklerini de vurgulayan Kaptan, “Film içindeki aktif maddenin yani tarçın yağının ortama salınması veriminde yüzde 70 oranına ulaştık. Etken maddeyi yara koşullarına ne kadar fazla verebilirsek daha fazla anti bakteriyel iyileştirme olanağı sağlanacağından bu oranı yükseltmek istiyoruz” şeklinde konuştu.
“4 ARKADAŞ BİRLEŞİP İNSANLARIN YARALARINA İYİ GELEBİLMEK İÇİN ÇALIŞTIK”
Projede yer alan kimya mühendisliği 3’üncü sınıf öğrencisi Ayça Bankoğlu ise “4 arkadaş birleşip kronik hastalıklara sahip insanların yaralarına iyi gelebilmek için araştırma yaptık. Tarçın yağının anti bakteriyel özeliğini keşfettik ve bunun üzerine TÜBİTAK’a proje sunduk; projemiz seçildi. Tarçın yağının iyileştirme özelliği ile kronik hastalıklarda, seroz akıntılarda yaralar hızlı iyileşiyor ve hastanın lehine bir süreç başlıyor.
Projemizde, tarçın yağının anti bakteriyel özelliğini kullanarak yüzde 70 oranında bir verim aldık. Hedefimiz, bu oranı daha çok artırmak, bu yüzden çalışmalarımız hala devam ediyor. Çalışmamızda mikroküreler ve hidrojenler olarak iki farklı mekanizmayı birleştirerek yara bandı oluşturduk. Tarçın yağının anti bakteriyel, doğal ve çevreye zararsız olması onu tercih etmemizin en önemli nedenlerindendir” diye konuştu.
“SEROZ KISMI UZAKLAŞTIRARAK YARAYI TEDAVİ EDEBİLİYOR”
Ayça Bankoğlu, çalışmalarının içeriğine dair şöyle konuştu:
“Tarçın yağı yüklü hidrojelleri kullanarak anti bakteriyel özellikli iyileştirici yara bandı yapmayı amaçlayarak yola çıktık. Hidrojel dediğimiz yara örtümüzün içinde mikrokürelerimiz bulunuyor ve kürelerin içinde de tarçın yağı bulunuyor. Hidrojellerin emici ve gözenekli yapısı sayesinde yaradaki seroz kısmı uzaklaştırarak yarayı tedavi edebiliyor.”













